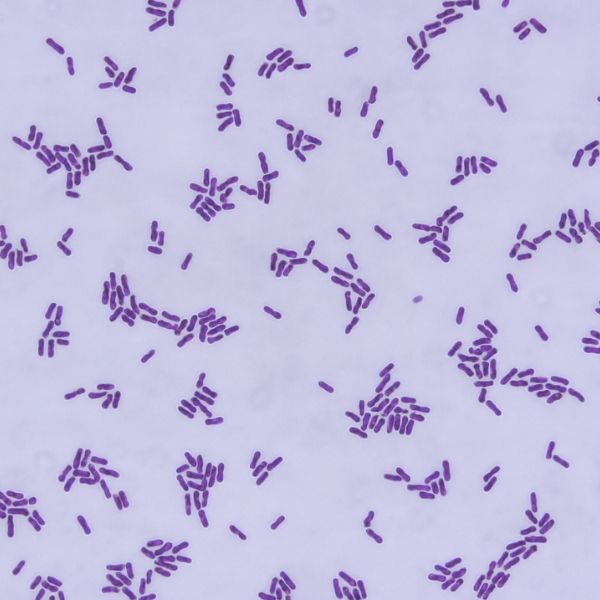

OUR INGREDIENTS
Nothing to Hide. Everything to Support You.
Pureffi combines over 30 proven ingredients, each transparently listed, each chosen for a reason. You could source them one by one. Or trust one clean scoop to bring it all together, every day.
Herbal Extracts & Adaptogens
Traditional botanicals to help you adapt and thrive

Ashwagandha
Ashwagandha is an adaptogen traditionally used to help the body cope with stress and support overall well-being.*

Grape Seed Extract
Grape seed extract is a rich source of oligomeric proanthocyanidins (OPCs), antioxidant compounds that help protect tissues from oxidative stress and support cardiovascular health.*

Black Cohosh
Black cohosh root extract is a traditional botanical that may help support relief from common menopausal symptoms like hot flashes and night sweats.*

Red Clover
Red clover extract provides isoflavones that support hormonal balance and comfort during perimenopause and menopause, including hot flash relief support. It also provides antioxidants that help protect the body from oxidative stress.*
Probiotics & Digestive Support
Nourish your gut, feel more at ease

Bifidobacterium bifidum
Bifidobacterium bifidum Bb-06® is a clinically studied probiotic strain that helps support digestive balance, immune function, and a healthy gut microbiota. It contributes to short-chain fatty acid production and supports regularity and intestinal comfort.*

Lactobacillus acidophilus
Lactobacillus acidophilus La-14® is a clinically studied probiotic strain that supports gut health, promotes women’s microbiota balance, and helps maintain normal immune function. It also contributes to digestive well-being and respiratory health.*
Bacillus subtilis
Bacillus subtilis (ATCC 122264) is a clinically studied, spore-forming probiotic that supports digestive comfort, promotes gut barrier function, and helps maintain a balanced microbiome and normal immune health. Its durable spore form ensures stability during manufacturing and survival through digestion.*

Chicory Root
Chicory root inulin is a soluble prebiotic fiber that helps support digestive health by promoting the growth of beneficial gut bacteria. It may also contribute to regularity and gentle laxation.*

BioPerine® Black Pepper Extract
BioPerine® is a patented black pepper extract standardized to contain 95% piperine, a bioactive compound known for its ability to enhance nutrient absorption. It helps improve the bioavailability of vitamins, minerals, and plant-based compounds, particularly those with low inherent absorption, such as curcumin and iron.*
Vitamins
Daily essentials for steady energy and resilience

Vitamin A
Retinyl palmitate is a preformed source of vitamin A that helps support vision, immune function, and skin health. It is a fat-soluble nutrient stored in the liver and converted in the body to active forms like retinol and retinoic acid.*

Vitamin C
Ascorbyl palmitate is a fat-soluble form of vitamin C that helps support antioxidant protection in both water- and fat-based tissues, unlike other forms that are only water-soluble. It promotes collagen formation, immune function, and iron absorption.*

Vitamin D3
Vitamin D3, the form made in the skin from sunlight, helps the body absorb calcium and phosphorus to build and maintain strong bones and teeth, and supports normal immune and muscle function.*

Vitamin E
Vitamin E is a fat-soluble antioxidant that helps protect cells from oxidative damage and supports immune function and skin health.*

Vitamin K2
Vitamin K2 as MK-7 is a highly bioavailable form that helps activate proteins important for bone mineralization, supporting bone strength, and may help inhibit arterial calcification to support heart health. Some studies suggest MK-7 may also support insulin sensitivity and metabolic health.*

Thiamin
Thiamin is a water-soluble B vitamin that supports the body’s energy production by helping convert carbohydrates into ATP. It also plays a role in nerve function and neurotransmitter synthesis, which supports cognitive health and mood.*

Riboflavin
Riboflavin is a water-soluble B vitamin that supports cellular energy production and plays a vital role in metabolizing carbohydrates, fats, and proteins. It also contributes to the maintenance of healthy skin, vision, and red blood cell formation.*

Niacin
Niacinamide is a form of vitamin B3 that helps the body turn food into energy and supports healthy skin and nervous system function—without the flushing effects sometimes caused by regular niacin.*

Biotin
Biotin is a water-soluble B vitamin (vitamin B7) that helps the body metabolize fats, carbohydrates, and amino acids for energy production. It also plays a key role in supporting healthy enzyme activity and is needed for the formation of glucose and fatty acids.*

Vitamin B5
D-calcium pantothenate is the stable form of vitamin B5, which helps the body produce coenzyme A—essential for turning food into cellular energy. It also supports red blood cell formation, adrenal function, and a healthy nervous system.*

Vitamin B6
Pyridoxine hydrochloride is a stable, well-absorbed form of vitamin B6 commonly used in dietary supplements. Vitamin B6 supports energy metabolism, brain function, and the body’s production of red blood cells.*

Vitamin B12
Methylcobalamin is the bioactive form of vitamin B12 that supports red blood cell production, neurological function, and DNA synthesis. It is essential for maintaining healthy homocysteine levels and plays a central role in cellular methylation processes that impact brain and nerve health.*
Minerals
Foundational minerals to keep you strong

Calcium
Calcium citrate is a highly bioavailable form of calcium that helps support strong bones, muscle function, nerve transmission, and cardiovascular health. It is especially useful for individuals who need a more easily absorbed form of calcium.*

Iron
Ferrous bisglycinate chelate is a well-absorbed form of iron that supports red blood cell production and healthy oxygen transport. This chelated form is more bioavailable than standard iron salts and is gentler on the stomach, making it a preferred choice for those sensitive to traditional iron supplements.*

Magnesium
Magnesium bisglycinate chelate is a well-absorbed, stomach-friendly form of magnesium that supports muscle function, stress balance, and cellular energy production. It’s known for its gentle effect on digestion and superior bioavailability compared to other forms.*

Zinc
Zinc citrate is a well-absorbed form of zinc that supports immune function, helps maintain healthy skin, and plays a role in the body's natural wound healing process. It also contributes to enzyme activity and nutrient metabolism essential for overall health.*

Selenium
Selenomethionine is a highly absorbable form of selenium, an essential trace mineral that supports antioxidant defenses and helps regulate thyroid hormones and immune activity. Selenium also contributes to DNA synthesis, reproduction, and cellular protection against oxidative stress.*

Copper
Copper gluconate is a bioavailable form of copper that supports red blood cell production, bone formation, and antioxidant defense. As a cofactor in several enzymes, copper helps the body metabolize iron, maintain immune function, and promote energy metabolism.*

Manganese
Manganese citrate is a bioavailable form of manganese, an essential trace mineral that supports bone formation, antioxidant activity, and nutrient metabolism. It acts as a cofactor for enzymes involved in collagen production and cellular defense against oxidative stress.*

Molybdenum
Molybdenum is an essential trace mineral that supports the activity of key enzymes involved in detoxification and nutrient metabolism. The amino acid chelate form may help enhance absorption and reduce gastrointestinal discomfort compared to inorganic salts.*

Potassium
Potassium is an essential mineral and electrolyte that supports fluid balance, heart rhythm, and muscle and nerve function. The gluconate form is gentle on the stomach and less likely to cause digestive upset than some other potassium salts.*

Chromium
Chromium picolinate is a well-absorbed form of the trace mineral chromium, which supports healthy metabolism by enhancing the action of insulin, the hormone responsible for regulating blood sugar.*

Folate
This is a bioactive form of folate that the body can use directly, without the conversion steps required by synthetic folic acid. Some individuals may benefit from this form’s higher usability. Folate supports red blood cell production, DNA repair, and healthy methylation, which are important for energy and hormone balance.*